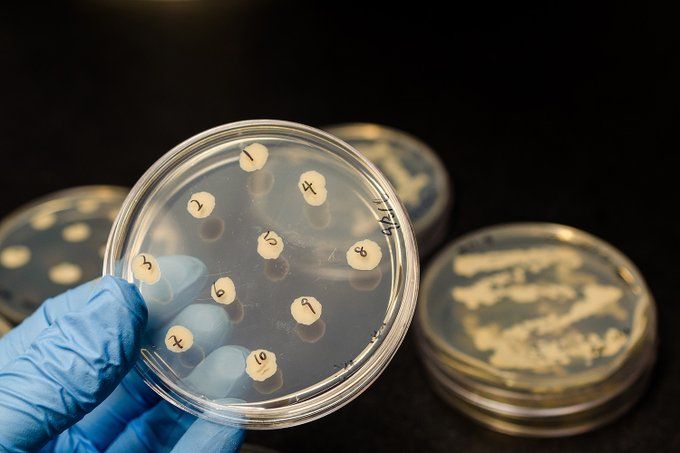
تطوير مضاد حيوي يحتفظ بالبكتيريا النافعة

شكرا لمتابعتكم وقرائتكم خبر عن تطوير مضاد حيوي يحتفظ بالبكتيريا النافعة والان مع التفاصيل
الخليج 365 - الرياض- احمد حسان - الخليج 365_واس
تمكّن باحثون بجامعة “إلينوي” الأمريكية، من تطوير مضاد حيوي جديد يتميّز بتركيزه على مسببات الأمراض دون التأثير على البكتيريا النافعة بالأمعاء.
وأفاد الباحثون في دراستهم المنشورة بدورية “Nature” العلمية، أن المضاد الحيوي الذي يحمل اسم “lolamicin” نجح في قتل 130 سلالة من البكتيريا المقاومة للأدوية، إلا أنه ترك الأنواع الأخرى المسؤولة عن عملية التمثيل الغذائي بالجسم.
ويختلف هذا المضاد الحيوي الجديد عن مثيلاته المعروفة الأخرى، مثل مضادات الأموكسيسيلين والكليندامايسين واسعة الطيف، حيث لا يسبب أي تغيير جوهري في ميكروبيوم الأمعاء.
ويفتح الاكتشاف الباب أمام العلماء لتلافي الآثار الجانبية الشائعة للمضادات الحيوية التقليدية، والتي لا تستطيع التفريق بين البكتيريا الموجبة والسالبة أثناء قيامها بالتخلص من مسببات الأمراض.
نسخ الرابط تم نسخ الرابط